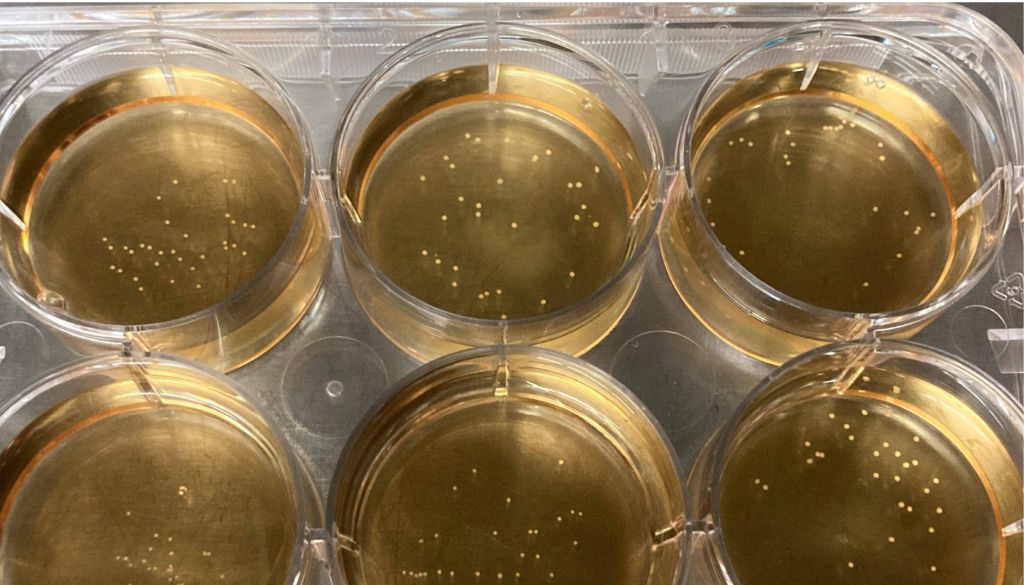

«Minicerebros» 3D que ayudan al estudio de la adicción a medicamentos de dolor
Los «minicerebros» creados en laboratorio ayudan a los científicos de la Clínica Mayo a arrojar luz sobre los objetivos terapéuticos para la adicción a los opioides. Los científicos de la Clínica Mayo desarrollaron hace 20 años modelos de cerebro en 3D en miniatura cultivados en laboratorio, a partir de células humanas para estudiar la adicción […]
Conoce la nueva técnica quirúrgica para tratar la neuralgia del trigémino

La Clínica Mayo informó hoy que está utilizando una nueva técnica quirúrgica para tratar la neuralgia del trigémino. Según define la Clínica, «la neuralgia del trigémino es una afección que provoca sensaciones dolorosas similares a una descarga eléctrica en un lado de la cara. Esta afección de dolor crónico afecta el nervio trigémino, que trasmite […]
Mayo Clinic colabora con compañía para transformar globalmente la atención al paciente

La ciencia de datos innovadora permitirá a los pacientes recibir una medicina personalizada, predictiva y proactiva Se trata de un acuerdo de colaboración de 10 años entre Mayo Clinic y Mercy, la primera alianza de su tipo entre dos grandes sistemas de atención médica; la cual utilizará la ciencia de datos más reciente y años […]
